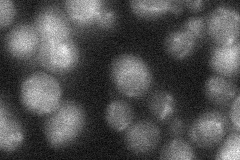
YDR105C
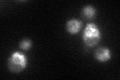
YDR105C

View description
Vacuolar membrane protein of unknown function that is conserved in mammals; predicted to contain eleven transmembrane helices; interacts with Pdr5p, a protein involved in multidrug resistance
Localization:
Intensity:
Fold change:
Significance:
-
C’ GFP library in SD

vacuole membrane31.18 -
N' NOP1pr-GFP in SD

punctate,vacuole membrane60.7428 -
N' TEF2pr-mCherry in SD

vacuole membrane147.787 -
N' NATIVEpr-GFP in SD
below threshold22.7092 -
N' TEF2pr-VC and Cyto-VN in SD

below threshold28.3741 -
C’ GFP library in SD+DTT
vacuole membrane40.251.29No -
C’ GFP library in SD+H2O2

vacuole membrane32.781.05No -
C’ GFP library in Starvation Media

vacuole membrane48.621.55Yes -
C’ GFP library on the background of Pup2-DaMP

vacuole membrane -
C’ GFP library on the background of CCT mutant

vacuole membrane33.52521.07492No
